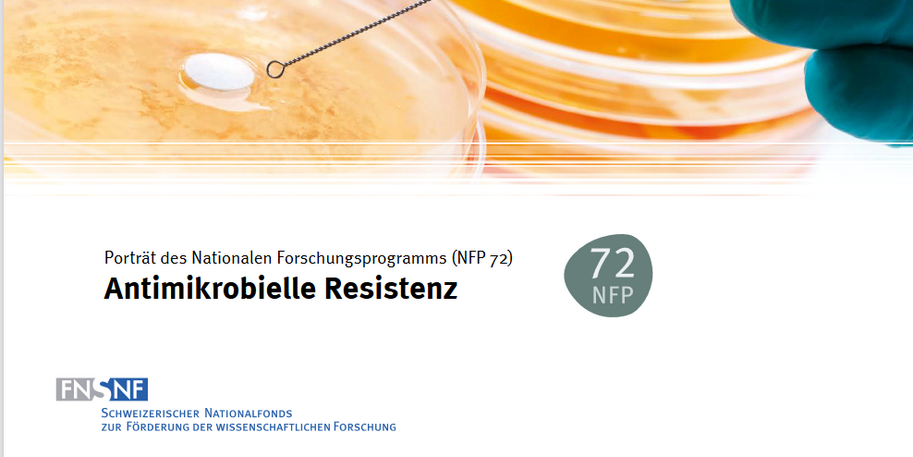

Interdisziplinarität im One Health Ansatz messbar gemacht
Das Schweizer Nationale Forschungsprogramm (NFP) 72 besteht aus interdisziplinären Projekten, die zu Resistenzen, Wirkstoffen und optimierten Antibiotikaeinsätzen forschen. Dem One-Health-Ansatz folgend bestehen die Teams aus unterschiedlichsten Disziplinen von Chemie über Medizin bis hin zu Sozialwissenschaften. inter 3 untersuchte im Auftrag der Universität Bern, welche Herausforderungen und Potenziale die Forschungsteams in dieser Art der Zusammenarbeit sehen.
Die Begleitforschung verfolgte das Ziel, die Formen der interdisziplinären Zusammenarbeit zu beleuchten und spezifische Anforderungen an die Forschungsförderung herauszuarbeiten. inter 3 entwickelte dazu ein passendes Studiendesign, das eine quantitative Onlinebefragung mit einer Dokumentenanalyse und Experteninterviews verband. Dabei kamen auch eigens entwickelte Skalen zur Messung der Intensität transdisziplinärer Zusammenarbeit in Forschungsteams zum Einsatz. inter 3 führte die Befragung der Forschenden aus den 42 Projekten durch, wertete die Antworten aus und unterstützte die Uni Bern beim Verfassen des Abschlussberichts.
Ein gemeinsames Forschungsverständnis ist herausfordernd, aber es lohnt sich
Die Forschung zu Antibiotikaresistenzen ist hochkomplex, an interdisziplinären Teams geht kein Weg vorbei. Große Herausforderungen sehen die Forschenden vor allem in der Koordination und der Herstellung eines gemeinsamen Forschungsverständnisses und einer gemeinsamen Sprache. Gleichzeitig zwingt diese Form der Zusammenarbeit zu einer stärkeren Selbstreflexion und öffnet so den Blick für neue Aspekte, Ideen und Lösungsansätze. Der One-Health-Ansatz ist noch sehr jung und gestaltbar. Um inter- und transdisziplinäre Zusammenarbeit gezielt unterstützen zu können, muss man zunächst genau verstehen, wie sie im konkreten Doing funktioniert.